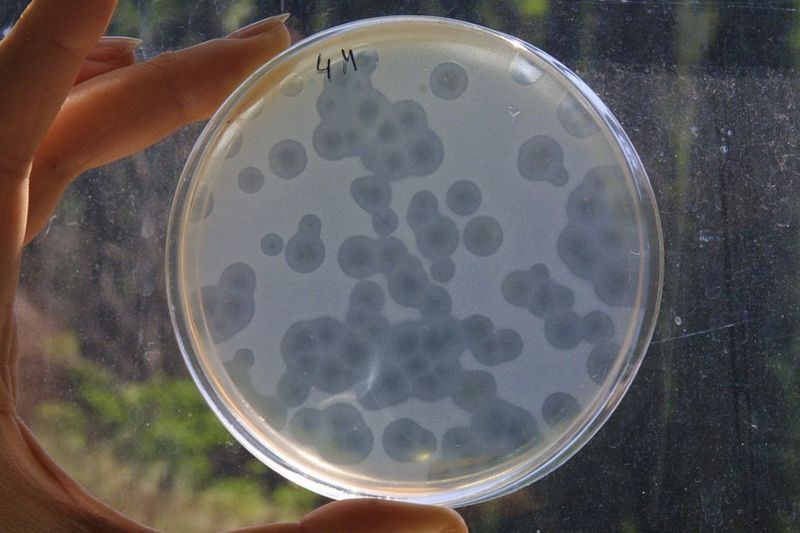

Bacteriófagos, los virus que se "comen" a las enfermedades humanas (y por qué muchos países no aprueban su tratamiento)

Hace tres años, los médicos le aconsejaron a Esteban Díaz que se inscribiera en la lista de trasplantes de pulmón después de batallar casi toda su vida contra la fibrosis quística.
La enfermedad causa una producción excesiva de moco en los pulmones y el páncreas, dejando a los pacientes extremadamente vulnerables a las infecciones bacterianas.
En el caso este francés de 47 años, los antibióticos que le habían recetado desde la infancia ya no eran eficaces contra las infecciones incesantes causadas por la Pseudomonas aeruginosa, una bacteria que ahora se clasifica como una superbacteria.
En cambio, Díaz (que no es su nombre real) viajó a Georgia, un antiguo estado soviético a orillas del mar Negro, para someterse a una terapia de fagos, un tratamiento médico que, según él, eliminó sus infecciones en unos días y lo alivió de la fatiga persistente, la tos incesante y la falta de aire que lo atormentó durante décadas.
¿Qué son los bacteriófagos?
Los virus bacteriófagos son aquellos que se aprovechan naturalmente de las bacterias al infectarlas y replicarse dentro de ellas hasta que estallan, matando a su huésped microbiano.
Hay miles de millones de fagos en la Tierra y han evolucionado conjuntamente con las bacterias de las que se alimentaron durante milenios, lo que ayuda a mantener su número bajo control.

Créditos: Getty Images
Su uso terapéutico fue iniciado por primera vez en 1919 por Felix d'Herelle, un microbiólogo franco-canadiense que utilizó fagos para curar a un niño que sufría de disentería grave.
Sin embargo, el descubrimiento de la penicilina en 1928 y su posterior producción comercial en la década de 1940 desató la era de los antibióticos, reemplazando efectivamente a la terapia con fagos.
El papel terapéutico de los fagos podría haber quedado en el olvido si no hubiese sido por la colaboración entre d'Herelle y George Eliava, un joven científico georgiano que había viajado a Francia en 1923.
Eliava llegó con el objetivo de estudiar el desarrollo de vacunas, pero en cambio dirigió su atención a los fagos después de conocer a d'Herelle en el Instituto Pasteur.
El joven regresó a Georgia e invitó a d'Herelle a ayudar a establecer el primer instituto de investigación y centro terapéutico del mundo dedicado a los bacteriófagos, justo cuando el país estaba siendo absorbido por la Unión Soviética.
Lamentablemente, como miles de intelectuales de la época, Eliava cayó en desgracia con el régimen de José Stalin y fue ejecutado en 1937.
Pero el patrocinio soviético de la investigación y el desarrollo de fagos terapéuticos continuó en el instituto que Eliava fundó, años después de que el mundo occidental dejara de lado el enfoque.

Créditos: VANO SHLAMOV/AFP/GETTY IMAGES
"La terapia con fagos era parte del sistema de atención médica estándar durante la Unión Soviética", dice Mzia Kutateladze, directora del Instituto Eliava.
"Dependiendo del estado de salud del paciente y del tipo de infección, los médicos determinarían si usar fagos, antibióticos o una combinación de ambos".
Sin embargo, el instituto enfrentó graves dificultades en los años posteriores a la desintegración de la Unión Soviética. Algunos investigadores recurrieron a almacenar cultivos de fagos en sus propios hogares para salvarlos.
Pero pronto el instituto jugaría un papel clave en la reintroducción al mundo del alcance y el potencial de la terapia con fagos.
"Pasó mucho tiempo antes de que la gente se convenciera de que los fagos se pueden usar con fines terapéuticos", asegura Kutateladze. "Pero la resistencia a los antibióticos respalda la necesidad de encontrar alternativas", añade.
Créditos: Getty Images
El instituto enfrentó enormes desafíos cuando comenzó a presentar su trabajo internacionalmente a fines de la década de 1990.
Pero en 2001, recibió a su primer paciente extranjero poco después de una conferencia en Montreal: un canadiense que padecía osteomielitis, una infección ósea bacteriana llamada que los antibióticos no habían podido curar.
El tratamiento funcionó y gracias a una avalancha de artículos de noticias que siguieron, pacientes de todo el mundo comenzaron a llegar al Instituto Eliava.
Resistencia a los antibióticos
La Organización Mundial de la Salud (OMS) ha calificado la resistencia a los antimicrobianos (RAM) como una crisis de salud global y estima que hasta 30 millones de personas se verán afectadas para el 2050.
Para los pacientes con fibrosis quística como Díaz, la resistencia a los antibióticos fue la consecuencia inevitable de una prescripción de por vida a las drogas.
"Desde que tenía 7 años hasta los 17… cada tres meses, me bombardeaban sistemáticamente con dos tipos diferentes de antibióticos; este era el protocolo en el pasado", describe Díaz.
Para cuando tenía 30 años, también había desarrollado tinnitus crónico como efecto secundario del uso continuo de aminoglucósidos, la familia de antibióticos más común que se usa para tratar infecciones por pseudomonas como la suya.
A los 40 años, la resistencia se había establecido y el trasplante doble de pulmón era la única opción que sus médicos en Francia podían sugerir para prolongar su vida.

Créditos: Pearly Jacob
Después de ver un documental sobre la terapia de fagos del Instituto Eliava en un canal de televisión francés reservó un vuelo.
"Al cuarto día de tratamiento fue como si alguien hubiera eliminado mi enfermedad. Dormí toda la noche por primera vez en años. Es difícil de describir... casi podía sentir el oxígeno corriendo por mis pulmones. Fue increíble", detalla.
Desde su primera visita, Díaz regresó regularmente a Tbilisi para abastecerse de dosis orales de preparaciones de fagos que han ayudado a mantener bajo control las infecciones posteriores.
Eso fue hasta que se quedó sin fagos en marzo de este año, justo cuando Georgia cerró sus fronteras en su esfuerzo por abordar la propagación del coronavirus.
Tan pronto como se aliviaron las restricciones de viaje, Díaz regresó para otra ronda de tratamiento que, según dijo, alivió de inmediato una tos persistente que había adquirido mientras tanto.
Problemas
Pero su tratamiento no ha estado exento de complicaciones.
Díaz teme perder sus beneficios si se descubre que ha viajado a Georgia para recibir tratamiento, especialmente durante una pandemia.
Agrega que sus médicos personales y un grupo líder de apoyo a la fibrosis quística en Francia también han advertido repetidamente a pacientes como él contra el uso de fagos para el tratamiento, ya que aún no está aprobado para su uso en los países occidentales.
Pero esto no ha detenido a cientos de pacientes extranjeros que buscan tratamientos con fagos en Georgia, con un puñado de agencias de viajes médicos especializados que los atienden.
El francés Alain Lavit y su esposa georgiana Irma Jejeia han estado ayudando a pacientes como Díaz a través de su agencia Caucasus Healing desde 2016.
La mayoría de sus clientes son franceses, y aunque algunos han hablado abiertamente con los medios sobre sus tratamientos con fagos, Lavit dice que los pacientes con enfermedades crónicas como la fibrosis quística prefieren mantener el anonimato debido a las complejas relaciones de por vida que desarrollan con sus médicos en sus países.
"No es ilegal ir al extranjero para recibir tratamiento, pero muchos de los pacientes con fibrosis quística con los que hemos trabajado están preocupados por ofender a sus neumólogos a quienes han visto desde la infancia y la mayoría de los médicos no saben nada sobre la terapia con fagos, por lo que siempre desaconsejan hacerlo", dice Lavit.
Una cláusula del sistema francés de pensiones por discapacidad, por ejemplo, estipula que los pacientes deben buscar empleo una vez que se recuperen de su enfermedad, lo que dificulta que las personas con enfermedades crónicas informen sobre cualquier mejora en sus síntomas.
"La terapia con fagos no los cura, pero ayuda a su condición", agrega Lavit.
Regulación
Millones de personas fueron tratadas con fagos en la Unión Soviética, y el Instituto Eliava continúa recibiendo y tratando exitosamente a cientos de pacientes internacionales cada año.
Pero han pasado poco más de dos décadas desde que los científicos occidentales reanudaron la investigación sobre la terapia con fagos y realizaron los ensayos clínicos necesarios para regular su uso como medicamentos terapéuticos.

Créditos: Getty Images
"Phagoburn" fue el primer ensayo clínico europeo dirigido por Francia de terapia con fagos en heridas por quemaduras infectadas siguiendo estrictas pautas médicas.
Financiado en parte con una subvención de 3,8 millones de euros (US$4,6 millones) de la Comisión Europea, funcionó entre 2013 y 2017, pero se canceló anticipadamente debido a razones que incluyen la imposibilidad de reclutar sujetos de prueba adecuados y problemas en la estabilidad de los fagos preparados.
Además, se necesitaron dos años y una cantidad significativa del presupuesto del proyecto para fabricar fagos de acuerdo con las Buenas Prácticas de Fabricación (BPF) prescritas.
Si bien el ensayo demostró que los fagos ayudaron a reducir la carga bacteriana en algunos pacientes, lo hicieron a un ritmo más lento que el tratamiento estándar.
Esto fue una decepción para los defensores de la terapia con fagos, incluidos los del Instituto Eliava.
"No es solo el fracaso de una prueba... afecta todo el concepto", dice Kutateladze, quien cree que el tipo de fagos, las dosis prescritas y el método de aplicación en la prueba no se adecuaron a la infección en los pacientes.
"Es muy difícil seguir la forma clásica estándar de aprobación. No es una fórmula química", agrega.
Los fagos deben coincidir con las bacterias que infectan para obtener resultados más efectivos, dice.
Las preparaciones médicas también deben actualizarse periódicamente, lo que dificulta que cumplan con las pautas occidentales establecidas que se diseñaron para los antimicrobianos convencionales.

Créditos: Pearly Jacob
"Se trata de biomedicinas y deberían beneficiarse de un estado separado, especialmente porque son naturales", dice Alain Dublanchat, uno de los principales defensores de la terapia con fagos en Francia, que a menudo ha remitido pacientes a la clínica del Instituto Eliava en Georgia.
Para él, el resultado de Phagoburn hizo aún más difícil para pacientes como Díaz hablar abiertamente sobre cómo los fagos ayudaron a curar sus infecciones en Francia.
"El principal obstáculo parece residir en la posibilidad de producir suspensiones de bacteriófagos que satisfagan a las autoridades sanitarias (francesas)", opina.
Agrega que la concentración de fagos utilizados en el estudio Phagoburn también se redujo para estar en el lado más seguro de las pautas de fabricación de medicamentos, un hecho mencionado en varios estudios de caso sobre las deficiencias del ensayo.
Uso compasivo de fagos
A pesar del revés de Phagoburn, el papel de los fagos en salvar las vidas del ciudadano estadounidense Tom Patterson y la paciente británica con fibrosis quística Isabelle Carnell-Holdaway de superbacterias mortales fue ampliamente difundido.
En ambos casos, los fagos fueron especialmente preparados y administrados bajo uso compasivo, cláusula que permite el uso de la medicina experimental como último recurso.

Créditos: Getty Images
Aunque varios países desarrollados, incluidos Reino Unido, Francia y EE.UU., permiten ahora el uso compasivo de fagos caso por caso, Dublanchet sostiene que esto excluye a muchas personas de recibir el tratamiento que necesitan desesperadamente.
"Parece absurdo esperar hasta que la vida de las personas haya llegado a una etapa precaria antes de que se nos autorice a (tratar) su enfermedad", analiza.
Bélgica está liderando el camino como el primer país desarrollado en aprobar el uso de fagos como preparaciones magistrales, o medicamentos personalizados que pueden ser preparados por un farmacéutico calificado según la prescripción de un médico.
"En Bélgica, pasamos muchos años discutiendo con los reguladores, pero esto fue un error", dice Jean Paul-Pirnay, director de investigación del Hospital Militar Reina Astrid (QAMH) en Bruselas.
"A los reguladores les gustaba la terapia con fagos, pero no tenían el poder ni el mandato para cambiar o reemplazar las regulaciones. Fue solo cuando el ministro de salud pública les pidió oficialmente que nos ayudaran que la pelota comenzó a rodar", detalla.
Pirnay es autor de un documento en el que se describen las recomendaciones para el Marco de Medicina de Fagos Magistrales de Bélgica, incluido un sistema regulador para crear un banco de semillas de fagos probados y certificados necesarios para preparaciones personalizadas.
Él dice que hay planes en curso para exportar esta solución a la Farmacopea Europea o una solución reguladora paneuropea que rige el uso de fagos, pero el covid-19 ha desacelerado el impulso.
Con estos desarrollos, Paul-Pirnay cree que es solo cuestión de tiempo antes de que la terapia personalizada con fagos sea aceptada como una opción de tratamiento estándar en todo el mundo.
Así lo describió en "Phage Therapy in the Year 2035", mitad artículo científico y mitad trama de ciencia ficción que retrata un futuro sombrío "caracterizado por la superpoblación humana, importantes alteraciones de los ecosistemas, el calentamiento global y la xenofobia", donde la Inteligencia Artificial ayuda a combatir las enfermedades al hacer coincidir los fagos adecuados a ellos.
Pero 2035 está demasiado lejos para las personas que están enfermas hoy. En la actualidad, unas 700.000 personas mueren cada año debido a infecciones de RAM.
Pirnay dijo que la alegoría futurista se insertó en su artículo para resaltar la urgente necesidad de una solución.
Aunque la OMS ha declarado repetidamente la necesidad de priorizar las alternativas a los antibióticos, nunca ha mencionado oficialmente el potencial de la terapia con fagos.
También hay una creciente demanda por parte de los científicos de fagos para que la OMS ayude a canalizar los fondos muy necesarios hacia más investigaciones clínicas y ensayos de fagos para uso terapéutico.
Aparte de los desafíos regulatorios, los fagos no se pueden patentar porque son productos biológicos.
Esto ha significado que la mayoría de las empresas farmacéuticas han evitado financiar la investigación para desarrollarlos como medicamentos.
Resistencia a los fagos
Las bacterias también pueden desarrollar resistencia a los fagos con el tiempo, un problema que los investigadores de fagos y los médicos han logrado eludir hasta ahora.
Lo hacen aislando nuevos fagos de los miles de millones de muestras disponibles en la naturaleza o entrenando fagos en laboratorios para desarrollar nuevas formas de atacar las bacterias.

Créditos: Getty Images
Este último es un proceso de coevolución en el que ambos microbios han formado parte durante milenios.
Una nueva investigación ha identificado la inmunidad defensiva llamada sistema Crispr-Cas que las bacterias desarrollan contra los fagos, proporcionando más pistas sobre cómo combatir la resistencia potencial.
Los laboratorios de investigación en países como EE.UU. están trabajando en los fagos modificados genéticamente y la extracción de lisinas, el agente activo en los fagos que matan las bacterias.
Esto a su vez ha despertado el interés de los gigantes farmacéuticos ya que estos métodos pueden patentarse, a diferencia de los fagos naturales que se utilizan actualmente para uso terapéutico.
El año pasado, Johnson & Johnson firmó un acuerdo inicial de US$20 millones con Locus Bioscience para investigar y desarrollar fagos mejorados diseñados con Crispr-Cas3 que podrían destruir los mecanismos defensivos que desarrollan las bacterias.
En medio del zumbido actual de la investigación moderna sin precedentes sobre fagos, el trabajo sólido y serio del Instituto Eliava se está pasando por alto lentamente, pero su contribución a la discusión mundial actual sobre los fagos no se puede negar, dice Pirnay, quien se refiere en broma al hecho de que su equipo incluye dos microbiólogos georgianos y que los llama "Eliava Brussels".
"El Instituto Eliava debería recibir más crédito por lo que hizo, pero también por lo que todavía está haciendo", opina.
Colaboración
Dado que los ensayos clínicos para fagos en Occidente son muy pocos y distantes entre sí, el Instituto Eliava ha comenzado a compartir en internet estudios de casos de sus pacientes.
Kutateladze espera que esto pueda ayudar a los demás a enfocar su investigación en asuntos más cruciales.
"En mi opinión, debería haber mucha más colaboración", dice. "Se ha gastado mucho tiempo y dinero en detalles que ya hemos investigado y documentado".

Créditos: ROMAIN LAFRABREGUE/AFP/GETTY IMAGES
El instituto colabora actualmente con el grupo suizo Ferring Pharmaceuticals y la empresa estadounidense Intralytix para investigar y desarrollar fagos para el tratamiento de problemas de salud reproductiva femenina.
También forma parte de un consorcio financiado por la UE para estudiar el uso potencial de fagos en el tratamiento del asma infantil.
Mientras tanto, el Instituto Eliava sigue siendo una de las únicas clínicas del mundo donde los pacientes pueden recibir tratamientos con fagos.
La clínica inició recientemente servicios de consulta en internet para ayudar a los pacientes desesperados que no pueden viajar a Georgia debido al covid-19.
El instituto también ha estado trabajando para actualizar sus instalaciones de producción para cumplir con los estándares de buenas prácticas de fabricación, una tarea desafiante para el instituto, a menudo con problemas de efectivo, pero que Kutateladze espera que en algún momento ayude a facilitar las exportaciones de sus preparaciones de fagos médicos a otros países.
Esta sería la solución ideal para pacientes como Díaz. Él prefiere viajar en persona a Tbilisi para renovar su stock de fagos y evitar que la aduana los intercepte y los elimine, como ha sucedido en el pasado cuando intentó que se los envíen por correo.
"Que la terapia con fagos no sea un tratamiento fácilmente disponible es el mayor escándalo de la medicina moderna", opina.
